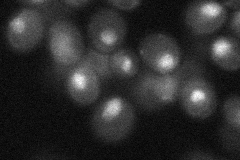
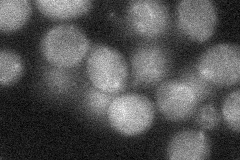

View description
Protein that binds DNA containing intrastrand cross-links formed by cisplatin, contains two HMG (high mobility group box) domains, which confer the ability to bend cisplatin-modified DNA; mediates aerobic transcriptional repression of COX5b
Localization:
Intensity:
Fold change:
Significance:
-
C’ GFP library in SD

below threshold17.86 -
N' NOP1pr-GFP in SD

nucleus124.545 -
N' TEF2pr-mCherry in SD

missing0 -
N' NATIVEpr-GFP in SD
nucleus34.2348 -
N' TEF2pr-VC and Cyto-VN in SD
below threshold25.5815 -
C’ GFP library in SD+DTT

cytosol15.580.87No -
C’ GFP library in SD+H2O2

cytosol17.240.96No -
C’ GFP library in Starvation Media

cytosol14.110.78No -
C’ GFP library on the background of Pup2-DaMP

below threshold -
C’ GFP library on the background of CCT mutant

below threshold17.59260.984824No
